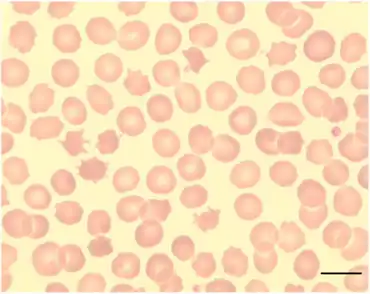

McLeod syndrome
| McLeod syndrome | |
|---|---|
| Other names: McLeod phenomenon | |
![]() | |
| McLeod syndrome is inherited in an X-linked recessive manner.[1] | |
McLeod syndrome (pronounced /məˈklaʊd/) is an X-linked recessive genetic disorder that may affect the blood, brain, peripheral nerves, muscle, and heart. It is caused by a variety of recessively inherited mutations in the XK gene on the X chromosome. The gene is responsible for producing the Kx protein, a secondary supportive protein for the Kell antigen on the red blood cell surface.
Signs and symptoms
Patients usually begin to notice symptoms in their 50s and the course is usually slowly progressive. Common features include peripheral neuropathy, cardiomyopathy, and hemolytic anemia. Other features include limb chorea, facial tics, other oral movements (lip and tongue biting), seizures, a late-onset dementia, and behavioral changes.
Genetics
The McLeod phenotype is a recessive mutation of the Kell blood group system. The McLeod gene encodes the XK protein, which is located on the X chromosome,[2] and has the structural characteristics of a membrane transport protein but an unknown function. Absence of the XK protein is an X-linked disease.[3] Mutational variants result in McLeod syndrome either with or without neuroacanthocytosis: the gene on the X chromosome for McLeod syndrome is physically close to the gene for chronic granulomatous disease. As a result, an individual with one relatively small deletion may have both diseases.[4]
The phenotype may be present without the syndrome presenting.[5]
Diagnosis
Laboratory features
McLeod syndrome is one of only a few disorders in which acanthocytes may be found on the peripheral blood smear. Blood evaluation may show signs of hemolytic anemia. Elevated creatine kinase can be seen with myopathy in McLeod syndrome.[6]
Radiologic and pathologic features
MRI shows increased T2 signal in the lateral putamen with caudate atrophy and secondary lateral ventricular dilation. Necropsy shows loss of neurons and gliosis in the caudate and globus pallidus. Similar changes may also be seen in the thalamus, substantia nigra, and putamen. The cerebellum and cerebral cortex are generally spared.
Treatment
There is no cure for McLeod syndrome; the treatment is supportive depending on symptoms. Medication may assist with management of epilepsy, and cardiac and psychiatric features, although patients may respond poorly to treatment for chorea.
Prognosis
A typical patient with severe McLeod syndrome that begins in adulthood lives for an additional 5 to 10 years. Patients with cardiomyopathy have elevated risk for congestive heart failure and sudden cardiac death. The prognosis for a normal life span is often good in some patients with mild neurological or cardiac sequelae.[7]
Epidemiology
McLeod syndrome is present in 0.5 to 1 per 100,000 of the population. McLeod males have variable acanthocytosis due to a defect in the inner leaflet bilayer of the red blood cell, as well as mild hemolysis. McLeod females have only occasional acanthocytes and very mild hemolysis; the lesser severity is thought to be due to X chromosome inactivation via the Lyon effect. Some individuals with McLeod phenotype develop myopathy, neuropathy, or psychiatric symptoms, producing a syndrome that may mimic chorea.[8][9]
McLeod syndrome can cause an increase in the enzymes creatine kinase (CK) and lactate dehydrogenase (LDH) found in routine blood screening.[10]
History
McLeod syndrome was discovered in 1961 and, as with the Kell antigen system, was named after the first patient in which it was found: Harvard dental student Hugh McLeod, whose red blood cells were observed to have weak expression of Kell system antigens during blood donation, and found to be acanthocytic (spiky) under the microscope.[11]
The wives of King Henry VIII of England show a pattern of pregnancies and infant deaths, which with his mental deterioration suggest that the king may have been Kell positive and suffered from McLeod syndrome.[12]
References
- ↑ Reference, Genetics Home. "McLeod neuroacanthocytosis syndrome". Genetics Home Reference. Archived from the original on 7 November 2017. Retrieved 1 November 2017.
- ↑ Arnaud L, Salachas F, Lucien N, et al. (March 2009). "Identification and characterization of a novel XK splice site mutation in a patient with McLeod syndrome". Transfusion. 49 (3): 479–84. doi:10.1111/j.1537-2995.2008.02003.x. PMID 19040496. S2CID 27198922.
- ↑ Ho MF, Monaco AP, Blonden LA, et al. (February 1992). "Fine mapping of the McLeod locus (XK) to a 150-380-kb region in Xp21". Am. J. Hum. Genet. 50 (2): 317–30. PMC 1682457. PMID 1734714.
- ↑ Marsh WL, Oyen R, Nichols ME, Allen FH (February 1975). "Chronic granulomatous disease and the Kell blood groups". Br. J. Haematol. 29 (2): 247–62. doi:10.1111/j.1365-2141.1975.tb01819.x. PMID 1191546. S2CID 34207654.
- ↑ Walker RH, Danek A, Uttner I, Offner R, Reid M, Lee S (February 2007). "McLeod phenotype without the McLeod syndrome". Transfusion. 47 (2): 299–305. doi:10.1111/j.1537-2995.2007.01106.x. PMID 17302777. S2CID 30836691.
- ↑ Butler C, Zeman AZ (March 2005). "Neurological syndromes which can be mistaken for psychiatric conditions". J Neurol Neurosurg Psychiatry. 76 Suppl 1: i31–38. doi:10.1136/jnnp.2004.060459. PMC 1765684. PMID 15718219.
- ↑ Hewer, E; Danek, A; Schoser, B. G.; Miranda, M; Reichard, R; Castiglioni, C; Oechsner, M; Goebel, H. H.; Heppner, F. L.; Jung, H. H. (2007). "Mc Leod myopathy revisited: More neurogenic and less benign". Brain. 130 (Pt 12): 3285–96. doi:10.1093/brain/awm269. PMID 18055495.
- ↑ Danek A, Rubio JP, Rampoldi L, et al. (December 2001). "McLeod neuroacanthocytosis: genotype and phenotype". Ann. Neurol. 50 (6): 755–64. doi:10.1002/ana.10035. PMID 11761473. S2CID 15051960.
- ↑ Malandrini A, Fabrizi GM, Truschi F, et al. (June 1994). "Atypical McLeod syndrome manifested as X-linked chorea-acanthocytosis, neuromyopathy, and dilated cardiomyopathy: report of a family". J. Neurol. Sci. 124 (1): 89–94. doi:10.1016/0022-510X(94)90016-7. PMID 7931427. S2CID 27859436. Archived from the original on 2021-03-19. Retrieved 2021-07-23.
- ↑ Oechsner M, G. Winkler G, A. Danek A, "McLeod neuroacanthocytosis: An underdiagnosed syndrome? Archived 2020-09-28 at the Wayback Machine" International communication forum in human molecular genetics September 6, 1995
- ↑ Allen FH, Krabbe SM, Corcoran PA (September 1961). "A new phenotype (McLeod) in the Kell blood-group system". Vox Sang. 6 (5): 555–60. doi:10.1111/j.1423-0410.1961.tb03203.x. PMID 13860532. S2CID 30275809.
- ↑ "Discovery News: Henry VIII's eccentricities possibly explained". Archived from the original on 2018-09-18. Retrieved 2021-07-23.
External links
- GeneReview/NIH/UW entry on McLeod Neuroacanthocytosis Syndrome Archived 2013-05-04 at the Library of Congress Web Archives
| Classification | |
|---|---|
| External resources |
|
